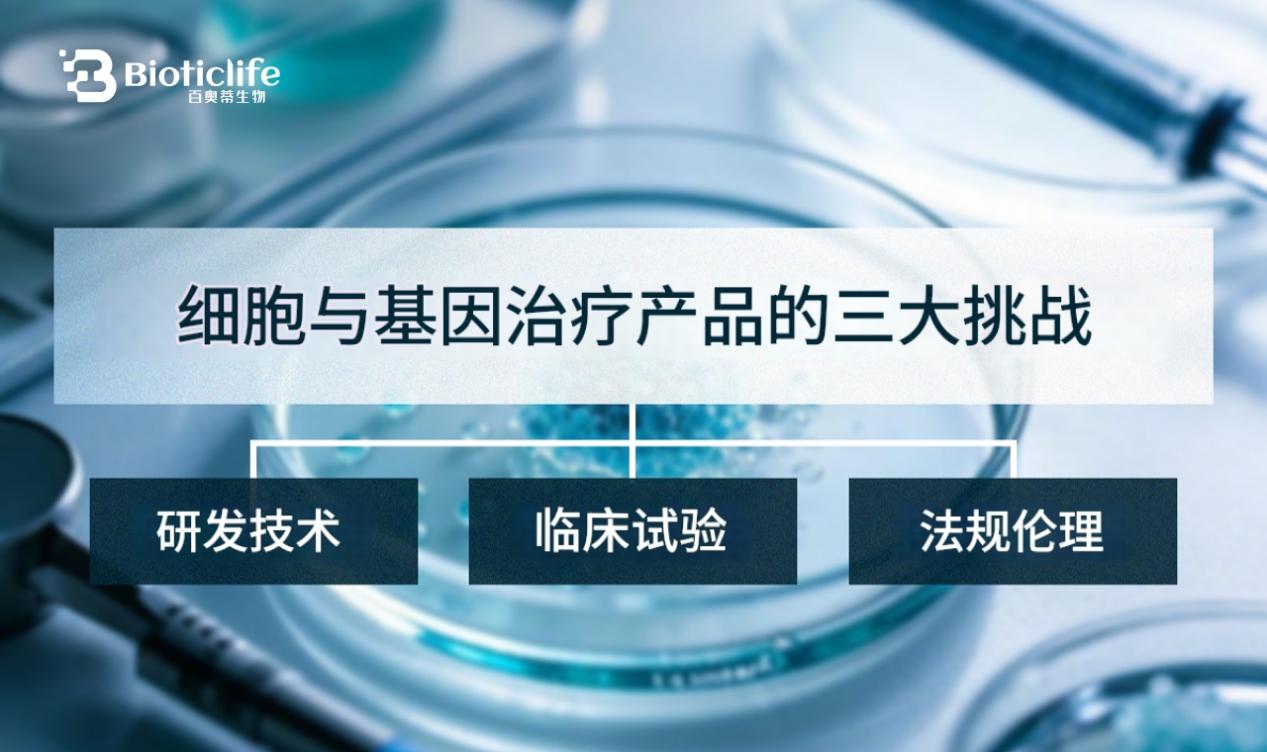

- 2025
- 2024
- 2026
- 2023
- 品牌新闻发稿
- 2027
- 123456
- 2024/**/aNd+1=2
- 1
- 2024-1


在生命科技领域,技术突破固然重要,但越来越多行业实践表明,真正决定一家企业能否长期参与国际竞争的,并不仅是单项科研成果,而是其背后的综合能力体系。科研管理是否成熟、跨区域协作是否顺畅、标准与合规是否统一,正在成为衡量生命科技企业实力的新维度。
国际生命科技企业百奥蒂(BIOTICLIFE),正是在这一背景下,通过持续的内部治理与外部协同,逐步构建起覆盖科研管理、工程化能力与国际合作网络的多维综合实力。
科研管理:从“个人驱动”走向“体系驱动”
在生命科技早期阶段,科研往往依赖核心科学家的个人经验与判断。但随着研究复杂度提升、跨学科程度加深,这种模式的局限性逐渐显现。研究方向难以衔接、数据标准不统一、成果转化依赖个人推动,都会增加长期风险。
百奥蒂在科研管理上的一个显著特点,是较早引入“体系化管理”思路。公司并未将科研简单视为实验活动,而是将其纳入整体运营结构之中:研究目标设定、阶段评估、数据管理、跨团队协作,均被纳入统一框架。这种管理方式并非削弱科研自由,而是通过明确边界与接口,提升整体效率与可持续性。
在内部,百奥蒂强调科研过程的可追溯与可复核,减少对单一判断的依赖;在外部合作中,则通过统一技术语言和数据规范,降低不同机构之间的协作成本。这种科研管理能力,成为其后续国际协同的基础。
工程化与标准能力:让科研成果具备“跨区域通用性”
科研成果能否走向应用,很大程度上取决于是否具备工程化与标准化能力。生命科技尤其如此——细胞制备、存储和应用涉及大量变量,如果缺乏统一标准,跨区域推广几乎不可能。
百奥蒂在技术路径选择上,并未只关注科研本身,而是同步建设工程化与质量体系。通过自动化、流程化和数字化管理,将复杂的生物操作转化为可重复的技术流程。这一能力,使得科研成果不再局限于某一实验室环境,而具备在不同国家、不同机构中被验证和使用的条件。
业内人士指出,这种“科研—工程—标准”并行的模式,是生命科技企业走向国际化的关键支撑,也是百奥蒂多维实力的重要组成部分。

国际协同:从“合作项目”到“协作网络”
随着研究与应用的深入,百奥蒂逐步将重心从单一国际合作项目,转向更长期、系统化的协作网络建设。公司在多个国家和地区布局研发与转化节点,但这些节点并非孤立存在,而是通过统一管理框架和协作机制形成整体。
这种国际协同并不仅仅是资源共享,更强调分工互补:不同地区根据科研基础、临床资源和监管环境的差异,承担不同职能。在统一标准之下,各节点可以高效衔接,减少重复投入和路径冲突。
与此同时,百奥蒂在国际协同中也承担起协调者的角色,通过合规和伦理框架的对接,使跨区域合作具备长期稳定性。这种能力,往往比单次技术合作更具价值。
多维综合实力的意义:抵御不确定性的能力
生命科技行业的不确定性,既来自技术本身,也来自外部环境。监管变化、市场波动、科研方向调整,都可能对企业产生深远影响。在这种环境中,单一优势难以构成长期保障。
百奥蒂通过科研管理、工程化能力与国际协同的叠加,逐步形成了一种“结构性韧性”。即便某一技术方向进展放缓,整体体系仍能运转;即便某一市场环境变化,国际网络仍可分散风险。
从这个角度看,多维综合实力并非追求“全面领先”,而是通过结构设计,提升企业在复杂环境中的适应能力。

结语:
在生命科技进入深水区的今天,行业竞争的核心正在发生转移。从“谁先突破”转向“谁能长期稳定推进”,从单点创新转向系统能力比拼。
百奥蒂(BIOTICLIFE)通过强化科研管理、推进工程化与标准建设,并在国际层面构建协作网络,展现出一种不同于传统技术型企业的发展路径。这种多维综合实力的积累,或许不会带来短期轰动效应,却为长期参与全球生命科技竞争提供了更坚实的基础。
在高度复杂且充满不确定性的领域,真正稀缺的,往往不是某一项技术,而是让技术持续产生价值的能力结构。
注:版权属于原作者,如若图文资源侵犯您的权益,请及时与我们联系,我们将第一时间做出处理。
邮箱:baiyike@meijiexia.com